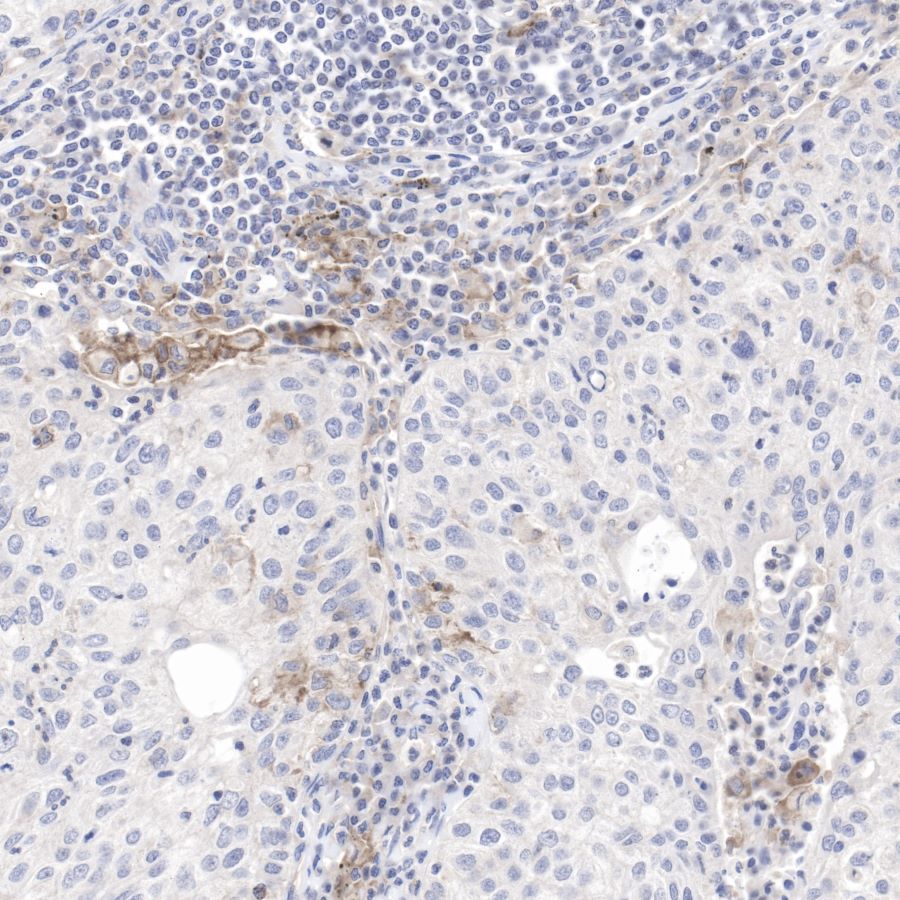

WB result of PD-L1 Rabbit mAb
Primary antibody: PD-L1 Rabbit mAb at 1/1000 dilution
Lane 1: A549 whole cell lysate 20 µg
Lane 2: A549 treated with IFN γ(100ng/ml, 48h) whole cell lysate 20 µg
Lane 3: MDA-MB-231 whole cell lysate 20 µg
Lane 4: U-87 MG whole cell lysate 20 µg
Secondary antibody: Goat Anti-Rabbit IgG, (H+L), HRP conjugated at 1/10000 dilution
Predicted MW: 40~50 kDa
Observed MW: 40~50 kDa
Exposure time: 120 s(This blot was developed with high sensitivity substrate)
Product Details
Product Details
Product Specification
| Host | Rabbit |
| Antigen | PD-L1 |
| Synonyms | CD274, B7-H1 |
| Immunogen | Recombinant Protein |
| Location | Membrane |
| Accession | Q9NZQ7 |
| Clone Number | SDT-119-16 |
| Antibody Type | Rabbit mAb |
| Application | WB, IHC-P, IF |
| Reactivity | Hu |
| Purification | Protein A |
| Concentration | 0.5 mg/ml |
| Physical Appearance | Liquid |
| Storage Buffer | PBS, 40% Glycerol, 0.05%BSA, 0.03% Proclin 300 |
| Stability & Storage | 12 months from date of receipt / reconstitution, -20 °C as supplied |
Dilution
| application | dilution | species |
| WB | 1:1000 | |
| IHC-P | 1:100-1:500 | |
| IF | 1:100 |
Background
Programmed death-ligand 1 (PD-L1) also known as cluster of differentiation 274 (CD274) or B7 homolog 1 (B7-H1) is a protein that in humans is encoded by the CD274 gene. Programmed death-ligand 1 (PD-L1) is a 40kDa type 1 transmembrane protein that has been speculated to play a major role in suppressing the adaptive arm of immune systems during particular events such as pregnancy, tissue allografts, autoimmune disease and other disease states such as hepatitis. The binding of PD-L1 to the inhibitory checkpoint molecule PD-1 transmits an inhibitory signal based on interaction with phosphatases (SHP-1 or SHP-2) via Immunoreceptor Tyrosine-Based Switch Motif (ITSM). This reduces the proliferation of antigen-specific T-cells in lymph nodes, while simultaneously reducing apoptosis in regulatory T cells (anti-inflammatory, suppressive T cells) - further mediated by a lower regulation of the gene Bcl-2. Upregulation of PD-L1 on immune cells (especially myeloid cells) can also lead to formation of an immunosuppressive environment in a highly localized manner that also allow the cancer cells to proliferate.
Picture
Picture
Western Blot

Immunohistochemistry

IHC shows positive staining in paraffin-embedded human tonsil.
Anti-PD-L1 antibody was used at 1/100 dilution, followed by a Goat Anti-Rabbit IgG H&L (HRP) ready to use.
Counterstained with hematoxylin.
Heat mediated antigen retrieval with Tris/EDTA buffer pH9.0 was performed before commencing with IHC staining protocol.

IHC shows positive staining in paraffin-embedded human placenta.
Anti-PD-L1 antibody was used at 1/100 dilution, followed by a Goat Anti-Rabbit IgG H&L (HRP) ready to use.
Counterstained with hematoxylin.
Heat mediated antigen retrieval with Tris/EDTA buffer pH9.0 was performed before commencing with IHC staining protocol.

IHC shows positive staining in paraffin-embedded human lung cancer.
Anti-PD-L1 antibody was used at 1/100 dilution, followed by a Goat Anti-Rabbit IgG H&L (HRP) ready to use.
Counterstained with hematoxylin.
Heat mediated antigen retrieval with Tris/EDTA buffer pH9.0 was performed before commencing with IHC staining protocol.

IHC shows positive staining in paraffin-embedded human lung cancer.
Anti-PD-L1 antibody was used at 1/100 dilution, followed by a Goat Anti-Rabbit IgG H&L (HRP) ready to use.
Counterstained with hematoxylin.
Heat mediated antigen retrieval with Tris/EDTA buffer pH9.0 was performed before commencing with IHC staining protocol.

IHC shows positive staining in paraffin-embedded human cervix cancer.
Anti-PD-L1 antibody was used at 1/100 dilution, followed by a Goat Anti-Rabbit IgG H&L (HRP) ready to use.
Counterstained with hematoxylin.
Heat mediated antigen retrieval with Tris/EDTA buffer pH9.0 was performed before commencing with IHC staining protocol.
Immunofluorescence

IF shows positive staining in paraffin-embedded human tonsil. Anti-PD-L1 antibody was used at 1/100 dilution (Green) and incubated overnight at 4°C. Goat polyclonal Antibody to Rabbit IgG - H&L (Alexa Fluor® 488) was used as secondary antibody at 1/1000 dilution. Counterstained with DAPI (Blue). Heat mediated antigen retrieval with EDTA buffer pH9.0 was performed before commencing with IF staining protocol.

IF shows positive staining in paraffin-embedded human lung squamous cell carcinoma. Anti-PD-L1 antibody was used at 1/100 dilution (Green) and incubated overnight at 4°C. Goat polyclonal Antibody to Rabbit IgG - H&L (Alexa Fluor® 488) was used as secondary antibody at 1/1000 dilution. Counterstained with DAPI (Blue). Heat mediated antigen retrieval with EDTA buffer pH9.0 was performed before commencing with IF staining protocol.